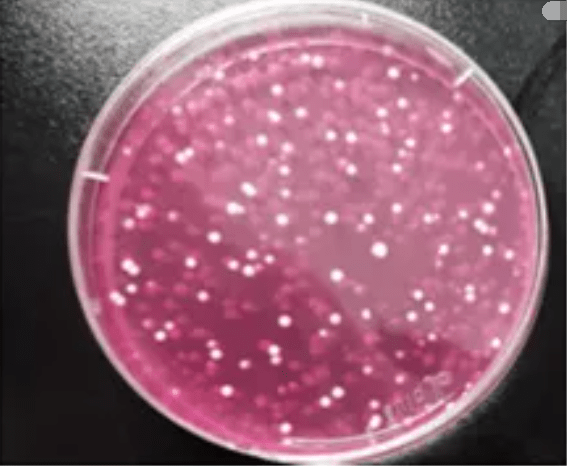

实验背景与目的
在日常生活中,我们的手经常接触到各种物体,如门把手、手机、电脑键盘等。这些物体表面可能存在着大量的微生物,包括细菌、真菌等。为了了解我们手上的菌落情况,我们可以进行一项简单的手上菌落实验。这项实验的目的是探究我们手上的微生物种类和数量,以及不同生活习惯对菌落分布的影响。
实验材料与工具
进行手上菌落实验所需的材料包括: - 无菌棉签 - 无菌生理盐水 - 灭菌培养皿 - 琼脂培养基 - 酵母提取物葡萄糖琼脂(YPG)培养基 - 紫外灯 - 显微镜 - 研钵和研杵 - 酒精灯 - 火柴 实验工具包括: - 电子天平 - 离心机 - 恒温培养箱 - 热水浴锅 - 显微镜载物台 - 移液器 - 滴管
实验步骤
1. **采样准备**:在实验前,确保双手清洁,避免污染采样工具。 2. **采样**:用无菌棉签在双手的不同部位(如指尖、手掌、手背)轻轻擦拭,然后将棉签插入装有生理盐水的试管中,轻轻摇晃,使菌落悬浮在生理盐水中。 3. **稀释**:将含有菌液的棉签取出,滴一滴在无菌培养皿中,然后加入适量的YPG培养基,用无菌玻璃棒轻轻搅拌,使菌液与培养基充分混合。 4. **涂布**:将混合好的培养基均匀涂布在培养皿表面,待其凝固。 5. **培养**:将涂布好的培养皿放入恒温培养箱中,培养24-48小时,观察菌落生长情况。 6. **计数**:使用显微镜观察培养皿上的菌落,记录菌落数量。 7. **分析**:根据菌落数量和种类,分析手上菌落的情况。
实验结果与分析
实验结果显示,每个人的手上菌落情况都有所不同。以下是一些常见的菌落种类及其分析: - **表皮葡萄球菌**:这是最常见的菌落之一,通常无害,但过多可能引起感染。 - **金黄色葡萄球菌**:这种菌落可能导致皮肤感染,如脓疱、疖等。 - **大肠杆菌**:虽然大肠杆菌通常与肠道相关,但手上也可能存在,尤其是在洗手不彻底的情况下。 - **真菌**:如念珠菌,可能导致手部皮肤感染,如香港脚。 通过分析不同部位菌落的分布情况,我们可以发现,指尖和手掌的菌落数量较多,这可能是因为这些部位与物体接触较多。此外,不同生活习惯(如洗手频率、饮食习惯等)也会影响手上菌落的分布。
实验结论
通过手上菌落实验,我们可以了解到手上的微生物种类和数量,以及生活习惯对菌落分布的影响。这有助于我们更好地了解自身健康状况,并采取相应的预防措施,如勤洗手、保持良好的个人卫生习惯等,以降低感染风险。
实验注意事项
在进行手上菌落实验时,需要注意以下几点: - 实验过程中要严格遵守无菌操作规程,避免污染。 - 实验结束后,要对实验器材进行彻底消毒,以防止交叉感染。 - 实验结果可能受到环境、个体差异等因素的影响,因此需要多次重复实验,以提高结果的准确性。
实验拓展
除了手上菌落实验,我们还可以进行其他相关实验,如: - 不同环境下菌落分布的比较实验 - 不同洗手方法对菌落消除效果的比较实验 - 食品接触表面菌落实验 通过这些实验,我们可以更全面地了解微生物在生活中的分布和影响,为公共卫生和个人卫生提供科学依据。
转载请注明来自醉美玉溪,本文标题:《手上菌落实验:手上菌落不能超过几个 》

蜀ICP备2022005971号-1
蜀ICP备2022005971号-1
还没有评论,来说两句吧...